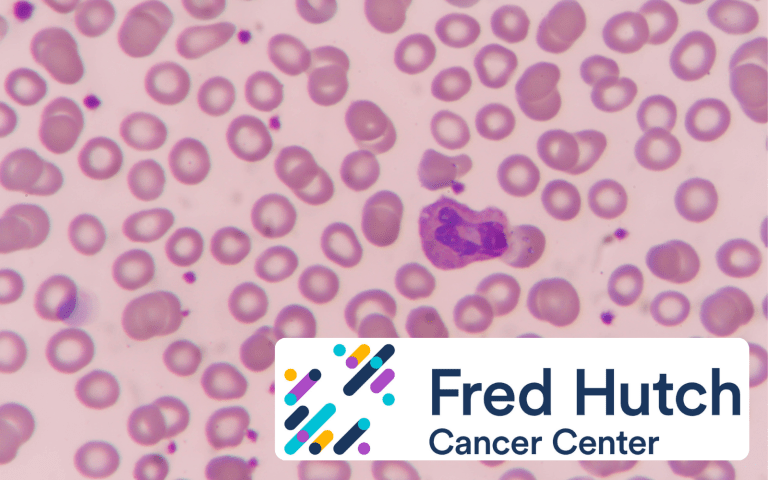

Q&A – Inside iDEM, Mytos’ Automated Cell Therapy Manufacturing Platform
Pluripotent stem cell therapies are expensive, upwards of $500K–$1M per dose. Mytos has developed an automated manufacturing platform to bring that down, it's currently being used by many companies, including Aspen Neuroscience for its iPSC-derived Parkinson's Phase 3. We sat down with co-founders Ali and Ignacio to hear how it works and where the company/industry is headed.

Regenerative medicine is nearing a tipping point.
Japan just made history by conditionally approving two iPSC-derived (induced pluripotent stem cell) therapies, companies are showing promise as they enter Phase IIIs, and keeping up with breakthroughs has become a full-time job.
But, there’s an elephant in the room: the cost of producing these therapies is astronomical, sometimes up to $1M per clinical-grade dose.
Get Regen Report in your inbox
Weekly updates on regenerative medicine news, trials, and regulatory moves.
Why is that? The answer is complicated, but a good parallel to draw from is automotive manufacturing. Every vehicle on the road, at one point, started off as a prototype. This requires purchasing one-off parts (the most expensive cost per unit), paying top-tier engineers for hands-on work, and after several iterations, you end up with a functional vehicle. The total cost for this can range anywhere from $250K-1M+ per vehicle.
Not until that vehicle reaches economies of scale will it become accessible for consumers.
Back to regenerative medicine, iPSC-derived therapeutics, though promising, are still very much so in that prototype phase. Most labs are producing artisanal batches for trials using manual workflows, which are labor-intensive, variable, and very expensive.
One company, Mytos, has developed a solution to bridge that gap from prototype to mass production, called iDEM (eye-dem).

iDEM is an automated, all-in-one adherent cell therapy manufacturing platform that ports familiar manual cell culture workflows into a closed, more repeatable system while preserving the flask-based biology many companies already use.
The pitch is straightforward: if therapies are going to move beyond promising early results, manufacturing has to become faster, more repeatable, and dramatically cheaper. Otherwise, as Mytos sees it, none of it will have an impact until it’s accessible to patients.
We sat down with co-founders Ali Afshar (CEO, left) and Ignacio Willats (CCO, right), who gave an inside look at the biggest bottlenecks in iPSC and tissue replacement manufacturing, how iDEM aims to solve these issues, and their current work automating production of Aspen Neuroscience’s neural cell therapy for its Phase III Parkinson’s trial launching this year.
Enjoy the interview!

What is the core problem Mytos is trying to solve?
Ali Afshar: These therapies are increasingly showing real promise, but the production is still very manual. That makes them expensive, hard to scale, and highly dependent on individual operator skill.
We hear the same pain points repeatedly. It can take six months to find someone skilled enough to run the process, another six months to train them to do it consistently in a clean room, and then, a year later, that person may even move on from their role because they did not get into science to spend all day gowned up performing repetitive tasks.
On top of that, clean rooms are expensive, batch density per footprint is limited, and operator variability can be a serious issue. One company told us they were seeing failure rates as high as 50% in one of their differentiation processes due to manual variability.
“Between labor intensity, training difficulty, clean room cost, and failure risk, you end up in a place where a therapy may be clinically compelling but economically impossible. That is the bottleneck we set out to address.“
What does the iDEM platform do?
Ignacio Willats: At a high level, iDEM automates the key steps of adherent stem cell culture while keeping the process close to what teams are already familiar with.
The operator loads the required reagents, and the platform then automates coating, feeding, passaging, harvesting, and imaging. It also includes onboard microscopy and cloud-based monitoring so teams can make more objective decisions around the culture rather than relying entirely on subjective human judgment.

What’s interesting is that a big part of variability comes from small manual actions that may seem trivial but matter a lot in practice. This would be things like:
- How hard do you tap the flask?
- How do you shake it to get the right seeding distribution?
- How do different operators interpret confluence?
Those details can have a major effect on the outcome. We often hear about one person on the team with “golden hands” who may not even be able to fully verbalize every detail, but somehow has the “feel” for it. They know how to handle the cells, when something looks right or wrong, etc. The problem is that you cannot build a scalable manufacturing operation around one expert.
What automation lets you do is take that know-how, turn it into a repeatable protocol, and then scale that. If done correctly, you end up with a more repeatable, consistent result with dramatically lower cost and hands-on time in the cleanroom. We’ve even seen up to 90% reductions in hands-on cleanroom time for some workflows.
Why does keeping the same flask setup matter so much?
Ali Afshar: It comes back to speed, which is a make-or-break point for many pre-revenue biotech companies.
Most are trying to reach the next trial, prove the therapy works, and unlock the next stage of funding. They cannot afford a multi-year detour just to redesign the biology around a new manufacturing modality. Our view is that if we build on the same flasks and culture the team is familiar with, the transition to automation is much faster.
Typically, a manual process can be transitioned onto our platform in around three runs and perform at least as well as it did manually. If you compare that with moving into a more traditional suspension bioreactor approach, the concern is that they may spend three to five years reworking the science just to get back to where they were. That is not attractive when time to the clinic is everything.
Can you talk about your work with Aspen Neuroscience?
Ali Afshar: Aspen has been a very important partner for us because they understand both the clinical promise and manufacturing reality, and their experts are getting ahead of the problems before they happen.
They’re gearing up for Phase III of their iPSC-derived dopaminergic neurons for Parkinson’s this year.
In short, they take patients’ skin cells, convert them into iPSCs, and then differentiate them into dopaminergic neuronal precursor cells, which are transplanted into the brain to hopefully restore dopamine production in Parkinson’s-affected patients.
Their Phase I/IIa was mostly manual, artisanal batches, and after evaluating multiple solutions to improve their production for Phase III, they chose iDEM to differentiate iPSCs into high-quality dopamine neuron precursors at scale.
We’re excited for iDEM to be used in Aspen’s production this year.
Can iDEM be used for other applications as well?
Ali Afshar: Yes, the platform is not limited to a single tissue type. We are seeing developers evaluate and use it across Parkinson’s, hearing restoration, corneal repair, bone repair, and many other areas.
The field is rapidly unlocking more and more use cases, and if those therapies are going to reach meaningful numbers of patients, again, scalability has to be built in early rather than treated as an afterthought.
What sort of work went into making iDEM “GMP-ready”?
Ali Afshar: Quite a lot, because GMP-readiness is not a single feature. It is a systems-level shift in how you design, build, qualify, and document the platform. That includes everything from traceability on consumables and sterility considerations to software integrity, signatures, and batch-level decision tracking.
More broadly, GMP is about ensuring consistent, high-quality production and managing risk, so we had to define detailed requirements across the system and verify that the platform could meet them reliably.
We also had to think deeply about the realities of the production environment itself. What does the operator experience in a clean room look like? How often do they need to interact with the system? What costs are associated with even small interventions? In some environments, an operator may spend 45 minutes gowning just to perform a minor action. Once you internalize that, product design changes. You start designing not just for scientific function, but for the lived reality of GMP manufacturing.
Could you talk about the recent launch of your automated CDMO model?
Ali Afshar: Most companies prefer to outsource to a CDMO rather than build out their own infrastructure. However, traditional CDMOs still use manual processes, which means the same labor, variability, and scale issues simply reappear in outsourced form.
Instead, we decided to get closer to our customers by launching our own automated CDMO built on iDEM. The first site is located at the CGT Catapult’s Stevenage Manufacturing Innovation Centre, about an hour north of London.

We’re targeting full clinical readiness by September 2026.
Because we’re now hands-on in commercial production, we’re also gaining unique insight into the real pain points of manufacturing various therapies and feeding them back to the R&D team. Every batch offers us an opportunity to learn something new and to continue lowering the cost per dose.
Beyond cost per dose, what are some of the other meaningful hurdles to mass adoption of regenerative medicine?
Ignacio Willats: Awareness is a big factor. Greater awareness of regenerative medicine inspires talent to enter the industry, drives more investment, and thus enables everyone to solve problems in novel ways. It kicks off the flywheel of adoption, and driving that is a big part of what we do.
Ali Afshar: I’d add another bottleneck that doesn’t receive as much attention is the administration of these therapies. Some of them are simply IV administration, but others, such as Aspen’s Parkinson’s trial, require brain implantation with specialized physicians and equipment. We’re seeing more and more companies design new medical devices and modalities to administer these cells in the right place, but it’s certainly another issue that will determine patient accessibility.
Special thanks to Ali and Ignacio for the interview! You can reach out for more information on their site here.